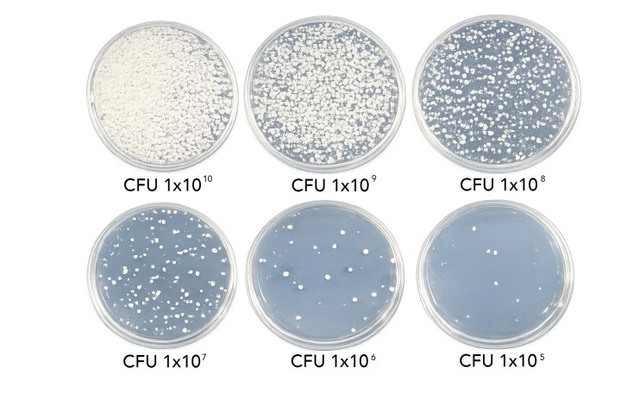

Colony Forming Units (CFU) are a regular topic of discussion among growers, particularly in the market for microbial biostimulants. The term is frequently mentioned here. However, according to microbiologist Marco Breekweg, many growers and advisers do not pay sufficient attention to it. "If it is used correctly, CFU is one of the most objective parameters available to compare microbial products both technically and economically," he says.
Breekweg, a microbiologist and supplier of microbial biostimulants under the brand name Biomicrobes, explains what CFU represents, how it is measured, and why it matters.
 © BiomicrobesMarco with his son Jelle in the lab, based in the Netherlands
© BiomicrobesMarco with his son Jelle in the lab, based in the Netherlands
What is CFU?
CFU stands for Colony Forming Units and indicates the number of living, viable micro-organisms capable of dividing and forming a colony. This applies to bacteria and fungi that are counted using plate or dilution methods. Importantly, CFU measurements only reflect living organisms. DNA-based methods such as qPCR or sequencing also detect non-viable organisms.
CFU counts are always strain-specific and are expressed on a logarithmic scale, such as 10⁶, 10⁸, 10⁹, or 10¹⁰. An increase of one log step does not represent a minor improvement, but a tenfold increase in active micro-organisms.
Although CFU is used for both bacteria and fungi, a fungal CFU represents more biological potential than a bacterial CFU. A single fungal CFU can develop into an extensive hyphal network. In commercial products, fungal CFUs usually consist of spores, as hyphae and mycelium have very limited survival outside a growth medium.
The role of test methods and dilution
Standard CFU testing methods were originally developed for the food industry, for example to determine the microbiological safety of milk and other products. To ensure reliable counting, samples are strongly diluted so that individual colonies become visible and countable on a nutrient medium.
In microbial biostimulants, this means biologically active products often undergo multiple dilution steps before plating. While dilution is necessary for technical counting, it may underestimate clustering and interactions between micro-organisms. As Breekweg notes, CFU measurements therefore represent a standardized approach rather than an exact reflection of biological complexity under practical growing conditions. "CFU remains a useful and comparable measure, as long as it is interpreted correctly."
How to read CFU numbers
© Biomicrobes
© Biomicrobes
- 1 × 105 CFU = 100,000 CFU per g or mL
- 1 × 10⁶ CFU = 1,000,000 CFU per g or mL
- 1 × 10⁸ CFU = 100,000,000 CFU per g or mL
- 1 × 10⁹ CFU = 1,000,000,000 CFU per g or mL
- 1 × 10¹⁰ CFU = 10,000,000,000 CFU per g or mL
For example, when 4x3 x 10⁸ CFU is specified, it means 4,300,000 CFU per gram or milliliter.
Mycorrhiza: propagules instead of CFU
For mycorrhizal products, CFU is generally not used. Instead, concentrations are expressed as propagules per gram or per milliliter (PPG). Mycorrhizal fungi are biologically much larger than bacteria and can develop from a single successful propagule into an extensive hyphal network.
"As a result, numerical concentrations in mycorrhizal products are considerably lower than in bacterial products," Marco explains. "A low PPG value does not mean a product is biologically weak. Comparisons are only meaningful when the same species, counting method, and unit of application are taken into account."
CFU is strain-specific
CFU values should only be compared when referring to the exact same microbial strain, according to the microbiologist. "A CFU value of Bacillus strain A cannot be compared with that of Bacillus strain B, even though they belong to the same species."
CFU in production, batch, and shelf life
CFU values represent a snapshot in time and can vary between batches. According to Breekweg, it is important to distinguish between CFU at production, CFU at the end of shelf life, and guaranteed minimum values.
"For growers, this is crucial because the product is applied at the end of the supply chain, not at the moment of production."
Combination products: interpretation requires extra care
Products that combine bacteria, fungi, and mycorrhiza require additional care when interpreting CFU and PPG values. These groups of micro-organisms differ in stability, survival, and rate of decline over time.
"In practice, they rarely have identical shelf lives and do not always remain equally stable during storage. This aspect is often underestimated. On paper, products may appear strong, but in application they can perform less consistently."
As a result, a total CFU or propagule claim in combination products often represents multiple, separate decline curves. For proper evaluation, each component should be assessed individually, considering the strain, guaranteed minimum value, and the point in time at which that value is guaranteed.
CFU per application unit
Ultimately, the biological impact is not determined by the CFU stated on the label, but by the number of CFU applied per hectare, per plant, or per irrigation event. The combination of concentration and dosage determines the actual microbial input.
The economic key point: CFU per dollar
Here, Marco gives an example.
Product A is priced at $25 per liter. The concentration is 1 × 10⁸ CFU/mL.
Product B (same strain) is priced at $50 per liter. The concentration is 1 × 10⁹ CFU/mL.
"Although Product B is more expensive per liter, it delivers ten times more active micro-organisms. When expressed as cost per billion CFU, Product B is clearly more economical."
CFU and PPG are not marketing terms but hard technical parameters, Marco concludes his argument. According to him, anyone who wants to professionally evaluate microbial products should look at:
• strain or species
• CFU or propagule concentration
• measuring moment and minimum value
• CFU per application unit
• cost per billion CFU or per thousand propagules
"Technical knowledge of microbiology is therefore essential for the correct assessment and application of biological products."
For more information:
Biomicrobes
[email protected]
www.biomicrobes.com










